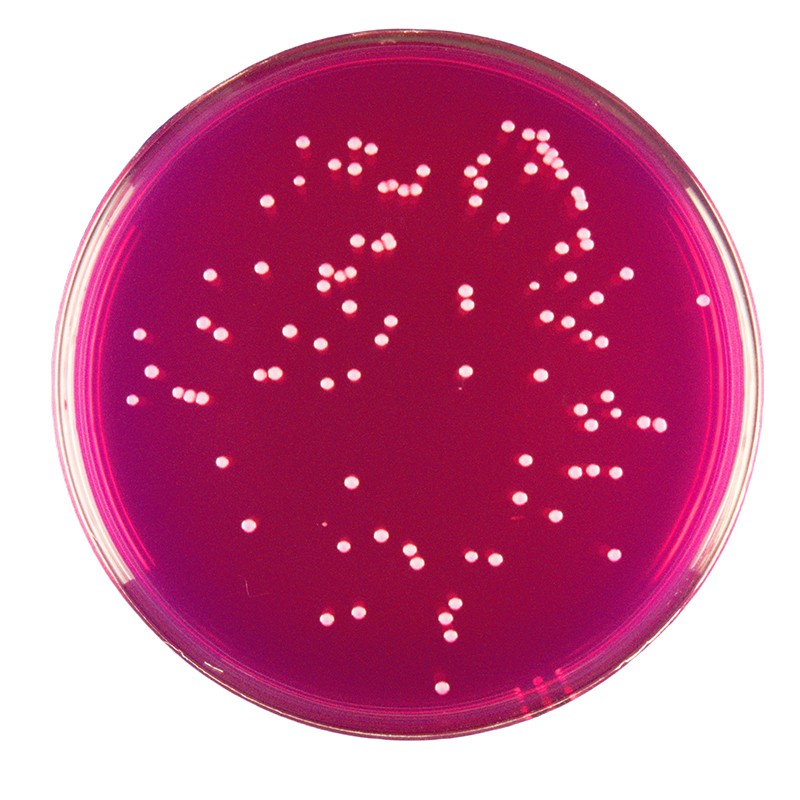

产品中心
虎红(孟加拉红)培养基
英文名称:Rose Bengal Medium
货 号 :K0156
规 格 :250g
价格:电询
用途:用于霉菌、酵母菌计数
浏览次数:408次
商品详细
说明书
同名产品
| 产品货号 | 产品名称 | 规格 | 产品说明及用途 |
|---|---|---|---|
| K0156 | 虎红(孟加拉红)培养基 | 250g | 用于霉菌、酵母菌计数 |
| K0156-2 | 虎红(孟加拉红)培养基 | 500g | 用于霉菌、酵母菌计数 |
| KM0024 | 虎红(孟加拉红)琼脂平皿 | 90mm、10皿/包 | 用于霉菌、酵母菌计数 |
| KM0024-1 | 虎红(孟加拉红)琼脂接触皿 | 55mm、10皿/包 | 用于霉菌、酵母菌计数 |

0513-85596088